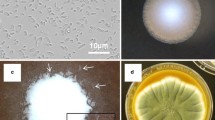

Abstract
Recent work suggests that Drosophila and Saccharomyces yeasts may establish a mutualistic association, and that this is driven by chemical communication. While individual volatiles have been implicated in the attraction of D. melanogaster, the semiochemicals affecting the behavior of the sibling species D. simulans are less well characterized. Here, we scrutinized a broad range of volatiles produced by attractive and repulsive yeasts to experimentally evaluate the chemical nature of communication between these species. When grown in liquid or on agar-solidified grape juice, attraction to S. cerevisiae was driven primarily by 3-methylbutyl acetate (isoamyl acetate) and repulsion by acetic acid, a known attractant to D. melanogaster (also known as vinegar fly). By using T-maze choice tests and synthetic compounds, we showed that these responses are strongly influenced by compound concentration. Moreover, the behavioral response is impacted further by the chemical context of the environment. Thus, chemical communication between yeasts and flies is complex, and is not driven simply by the presence of single volatiles, but modulated by compound interactions. The ecological context of chemical communication needs to be taken into consideration when testing for ecologically realistic responses.
Similar content being viewed by others
Explore related subjects
Discover the latest articles, news and stories from top researchers in related subjects.Avoid common mistakes on your manuscript.
Introduction
Chemical communication is the most ancient and widespread form of information transfer among organisms (Haldane 1955). As with other forms of two-way communication, such as sight and sound, chemical communication can influence behavior if the sender and receiver inherently and/or through learning ‘agree’ upon a signal-response relationship (Bergström 2008). True signals are directed and are thought to have evolved from unintentional precursors (cues), such as metabolic waste products (Steiger et al. 2011; Weiss et al. 2013).
It has long been known that Drosophila is attracted to fermenting yeasts (Dobzhansky et al. 1956), which produce a range of volatile metabolites, especially during fermentation. These volatiles have been most well studied for Saccharomyces cerevisiae, as this species is both a research model and a key microbe in the production of wine and beer where aroma-active fermentation volatiles are major contributors to flavor (Cordente et al. 2012; Styger et al. 2011). However, the biological role of yeast volatile production remains elusive (Saerens et al. 2010). Recent work demonstrates that yeast volatiles might act as semiochemicals mediating the attraction of insect vectors (Becher et al. 2012; Buser et al. 2014; Christiaens et al. 2014; Palanca et al. 2013; Witzgall et al. 2012). It is not only Drosophila that derives fitness benefits from accessing yeast-infested fruits (Anagnostou et al. 2010; Becher et al. 2012); insect attraction also has been shown to be selectively advantageous for yeasts in terms of increased dispersal (Buser et al. 2014; Christiaens et al. 2014). Experimental work suggests that: 1) the production of acetates by yeast can mediate attraction of Drosophila (Christiaens et al. 2014); 2) there is variance in attraction among different yeast species and genotypes of S. cerevisiae (Buser et al. 2014; Palanca et al. 2013); 3) attraction correlates with yeast dispersal both in the laboratory (Buser et al. 2014; Christiaens et al. 2014) and in the field (Buser et al. 2014); 4) increased attraction by yeasts is associated with increased Drosophila fecundity in fruits, demonstrating that volatile emission by attractive Saccharomyces initiates a mutualism with Drosophila (Buser et al. 2014).
Recent research in this area using D. melanogaster as a model species has focused primarily on the receptors involved in insect olfaction and on the volatiles that activate them. Systematic characterization of these receptors demonstrates that D. melanogaster is capable of sensing at least 100 volatiles (Hallem and Carlson 2006). A number of common yeast fermentation products, such as ethanol, acetic acid, ethyl acetate, 2-phenylethanol, 3-hydroxy-2-butanone (acetoin), 3-methylbutanol (isoamyl alcohol), and 3-methylbutyl acetate (isoamyl acetate) have been implicated in the attraction of D. melanogaster (Becher et al. 2012; Hutner et al. 1937; Joseph et al. 2009), which has much of its sensory apparatus tuned to volatiles produced by yeasts, especially esters (Hallem and Carlson 2004, 2006; Vosshall and Stocker 2007). Indeed, when yeasts’ ability to synthesise acetates is compromised, D. melanogaster attraction is significantly affected (Christiaens et al. 2014). While this research has been a significant step forward, such a gross change in volatile production capability might not reflect the complex ecological subtleties of the drivers of this interaction in nature.
Drosophila simulans belongs to the same subgroup as D. melanogaster (Drosophila 12 Consortium 2007), and is known to form hybrids and live in sympatry with its evolutionary sibling (Capy and Gibert 2004). One study (Stökl et al. 2010) describes the chemical drivers of deceptive pollination attraction of D. melanogaster and D. simulans to Solomon’s Lily (Arum palaestinum), and suggests attraction is mediated by a more complex bouquet of at least six compounds (2,3-butanediol acetate, acetoin acetate, hexyl acetate, ethyl hexanoate, 2-phenylethyl acetate, 2-phenylethanol). The most parsimonious hypothesis would be that the chemical language shaping yeast-fly mutualism is “simple” and mediated by either a single semiochemical or compound class, such as acetates. An alternate hypothesis might be that attraction is “complex” or multifactorial and context specific, perhaps comprising blends of behaviorally active volatiles (Becher et al. 2012; Stökl et al. 2010). Consequently, the inherent information of a chemical message would be not only contingent upon the chemical nature of the volatiles, but also on their relative abundance, and interaction with other semiochemicals and the background chemical matrix.
Buser et al. (2014) assayed the behavioral response of D. simulans to 100 genetically and ecologically diverse strains of S. cerevisiae and demonstrated a mutualistic association with the S. cerevisiae isolate ‘fly_KR_78.3’, which is attractive to this species, but not with the ‘DBVPG6044’ isolate (Liti et al. 2009), which is repulsive. Here, we analyzed the volatile profiles of these attractive and repulsive yeast isolates and experimentally evaluated whether the mutualistic association between S. cerevisiae and D. simulans is driven by simple or more complex forms of chemical communication.
Methods and Materials
Study Organisms
The D. simulans employed here originated from a natural vineyard population near Auckland, New Zealand, and is the same isofemale D. simulans line used by Buser et al. (2014). We followed Buser et al. (2014) and assayed the interaction between yeast and flies when grown in liquid and solidified (2:1 with 20 % agar) Sauvignon Blanc grape juice (derived from Marlborough, New Zealand), sterilized with 400 μl dimethyl dicarbonate (Sigma-Aldrich; dissolved in 800 μl ethanol) per liter.
Flies were kept in polypropylene Drosophila vials (www.flystuff.com) on plain Formula 4-24® instant Drosophila medium (Carolina, www.Carolina.com) and propagated at 25 °C and 12:12 Light:Dark cycle. The attractive Saccharomyces cerevisiae strain (‘fly_KR_78.3’) was isolated from a single D. simulans fruit fly (Buser et al. 2014) sampled at a different vineyard near Auckland, New Zealand, from which the isofemale D. simulans line was sourced. The repulsive S. cerevisiae isolate (‘DBVPG6044’) was kindly provided by Prof Edward Louis (University of Leicester, UK) and originated from a West African wine ferment (Liti et al. 2009). Yeasts were grown for 48 h (28 °C) in standard liquid YPD-medium (1 % yeast extract, 2 % peptone, 2 % glucose; BD-Difco). Sterilized liquid and agar-solidified grape juice was inoculated with 105 cells per ml and incubated for 48 h (28 °C; 200 rpm for liquid cultures).
Volatile Analysis
Total headspace volatile profiles from yeast ferments were analyzed to screen for compounds that may mediate D. simulans attraction and repulsion. Attractive and repulsive S. cerevisiae isolates were inoculated into liquid and solidified grape juice in triplicate to constitute biological replicates. In addition, three un-inoculated controls and one empty tube (blank) were included and sampled in parallel. All samples were analyzed using gas chromatography coupled with mass spectrometry (GC/MS).
After sample preparation, 1.25 μl of the internal standard (0.2 mg ml−1 [D8]-methyl benzoate in 70 % ethanol; Sigma-Aldrich) were added to each cell-free liquid ferment (2.5 ml supernatant in 100 ml glass tube), on the surface of the solidified 2.5 ml juice-agar plates (35 × 10 mm; in 500 ml preserving jar) and respective sterile controls. A dynamic (purge and trap) headspace sampling approach was employed (23–25 °C), using purified air (BOC; 25 ± 0.2 ml min−1) to concentrate volatiles in adsorbent-filled (Tenax®-TA resin; 100 mg) direct thermal desorption vials (ATAS GL International). The sampling time was set for 2 h, and the Tenax® traps were submitted immediately for automated (Focus auto sampler, ATAS GL; PAL cycle composer software 1.5.4) GC/MS injection. Trapped volatiles were thermally desorbed (175 °C; ramp rate of 50 °C min−1; Optic 3 thermal desorption system, ATAS GL) and then cryo-focused at −120 °C using liquid nitrogen. The sample was injected in split mode (1:15 split for 3 min, then 1:25 split) to allow rapid homogenization with the carrier gas (Helium). Volatiles were transferred onto a 30 m × 0.25 mm × 0.25 μm film thickness DB-Wax (J&W Scientific, Folsom, CA, USA) capillary column in an HP6890 GC (Agilent Technologies). A linear GC-program of 3 °C min−1 from 35 °C hold for 2 min to 220 °C hold for 5 min was applied with a column flow of 1 ml min−1.
Time-of-flight mass spectrometry (TOF-MS, Leco Pegasus III, St. Joseph, MI, USA) was used for structure elucidation. The transfer line temperature was set to 220 °C, and a detector voltage of 1700 V was applied. The ion source temperature was kept at 200 °C, and an ionization energy of 70 eV was used for electron impact ionization. Spectra were collected from 26 to 250 amu with a data acquisition rate of 20 Hz s−1. Spectra of target compounds were matched to the National Institute of Standards and Technology (NIST) library. The identity of a compound present in different runs was based on comparison of its mass spectrum and retention time. Single peaks were selected manually for integration (LECO chromaTOF software) and analyzed in equivalence to the internal standard. In total, the relative concentrations of 143 volatiles were semi-quantitatively evaluated in this way. 2-Methylbutyl acetate (2-MBA), 3-methylbutyl acetate (3-MBA, isoamyl acetate), and acetic acid were verified using authentic standards (Sigma-Aldrich) and directly quantified using a dilution series in grape juice following headspace sampling and GC/MS analysis as described above.
The separation of 2-MBA and 3-MBA was poor using a polar DB-wax column, and 2-MBA was found to contribute to a minor portion of the 3-MBA peak.
Volatile profiles of semi-quantified compounds were visualized with heat maps using the heatmap.2 function in R 2.15.0 (R Development Core Team 2008). The variance of individual compound levels (corrected against internal standard) from attractive and repulsive ferments was evaluated with Principal Component Analysis (PCA) using PAST 3.x (http://folk.uio.no/ohammer/past/). Differences in these semi-quantitative data were further analysed using t-tests applying Benjamini-Hochberg multiple testing correction with α = 0.2, (PBH).
Behavioral Study
To further study the context dependency of semiochemicals on D. simulans behavior, two-way (T-maze) choice tests (replicated six to eight times) were performed (30 min in the dark, 80 females, 3–6 day-old; 25 h starved). An attraction index (AI) was calculated following Buser et al. (2014), which calculates the proportion of flies found in either arm of the T-maze. Controls which assayed fly choice between sterile grape juice were included in every suite of assays to evaluate whether the experimental apparatus introduced a bias. The binominal distribution was used to test whether the dispersal of flies between both arms of the T-maze apparatus was significantly different from random expectations.
Results
Chemical Communication Is Modulated by Compound Concentrations
The original experiment that demonstrated the mutualistic interaction between attractive yeast isolates and Drosophila simulans utilized a liquid environment for yeast growth in the T-maze choice assays, and a solid environment for dispersal assays (Buser et al. 2014). We repeated these assays, and the attraction indices (AIs) for both liquid and solid media are almost perfectly associated when tested against un-inoculated grape juice control. The attractive S. cerevisiae (fly_KR_78.3) had an AI of 0.29 in liquid and 0.30 on solidified grape juice, and the repulsive S. cerevisiae (DBVPG6044) had an AI of −0.22 in liquid and −0.20 on solidified grape juice. We analyzed the volatile profiles of these attractive and repulsive S. cerevisiae isolates to screen for semiochemicals putatively involved in attraction and repulsion. GC/MS-analysis showed the liquid ferments were 92 %, and solid ferments 100 % identical, in terms of the presence/absence of 143 volatiles (measured across both systems; Fig. 1). However, the similarity of quantitative compositions of volatiles in liquid compared to solid grape juice medium was below 50 % for both yeast isolates, with varying amounts of individual compounds. Previously reported semiochemicals for yeast-mediated Drosophila attraction include ethanol, acetic acid, ethyl acetate, 2-phenylethanol, 3-hydroxy-2-butanone (acetoin), 3-methylbutanol (isoamyl alcohol), and 3-methylbutyl acetate (isoamyl acetate) (Becher et al. 2012; Cha et al. 2012; Christiaens et al. 2014). All of these compounds were identified in both, attractive and repulsive S. cerevisiae isolates when grown on liquid and agar-solidified grape juice. This first observation suggests that it might not just be the presence or absence of one or several compounds that drives chemical attraction and repulsion, but perhaps the relative abundance of compounds or some function of more complex compound interactions (“pattern recognition”, additive, antagonistic, synergistic, masking effects).
Volatile profiles of liquid (Juice) and solid (Agar) grape juice medium inoculated with Saccharomyces cerevisiae isolates attractive (Sc +) and repulsive (Sc −) to Drosophila simulans and sterile controls (C). Color-intensity indicates the mean relative volatile concentration (N = 3) as measured from the headspace of the ferment and uninoculated controls. Peak numbers are assigned according to GC-retention time
We went on to analyze both concentrations including single volatiles and volatile profile compositions to evaluate if any of these might be associated with insect attraction and repulsion. Analysis of the variance in concentrations of each of the compounds from both liquid and solid ferments with a simple t-test with a false discovery rate of 80 %, revealed that just 22 and 12 of the 120 (volatiles measured from liquid cultures) and 93 volatiles (quantified from juice-agar) differed significantly between the profiles of attractive and repulsive yeasts at P BH < 0.05 when grown on liquid and solid grape juice, respectively. Of those volatiles that significantly differed between attractive and repulsive yeasts, just three were common to both liquid and solid ferments. Concentrations of 2-phenylethyl acetate were different between attractive and repulsive yeasts but inconsistent between growth environments: in liquid environments, 2-phenylethyl acetate levels from attractive yeast were 2.5-fold higher but in solid environments they were 2.7-fold lower. However, acetic acid (AA) was consistently associated with repulsive yeast in both liquid and solid ferments, and levels were on average 3.2-fold (liquid) and 15-fold (solid) higher in the repulsive yeast’s profile (P BH < 0.03). In comparison to the repulsive strain, the attractive yeast consistently produced higher amounts of the predominant isomer 3-methylbutyl acetate (isoamyl acetate; 3-MBA) and of the minor component 2-methylbutyl acetate (2-MBA), which combined were 2.6-fold and 3.5-fold higher (P BH < 0.04) in liquid and solid ferments, respectively.
We next employed Principle Component Analysis (PCA) to simultaneously analyze all data to dissect the impact of subtle shifts in volatile composition on the chemical message impacting fruit fly behavior. The first component explains 94.3 % and 92.6 % of the variance in volatile profiles in liquid and solid ferments, respectively. The results of this multivariate approach are consistent with the univariate analyses in that the subset of fermentation volatiles correlating with differential Drosophila behavior differs depending on whether the ferments are conducted in a liquid or solid environment. According to these analyses, a subset of volatiles are associated with attraction across both systems: P15 (most likely 1,1-diethoxyethane), P37 (2-methylpropanol), P40 (3-MBA/2-MBA), P57 (3-methylbutanol), and P122 (2-phenylethanol). In comparison, P64 (3-hydroxy-2-butanone) and P80 (AA) were associated with repulsion. The same two compounds implicated in the analyses of single volatiles also are highlighted in the PCA analyses: 3-MBA/2-MBA and AA. Further, the polarity of these – greater concentrations of AA in the repulsive ferments and 3-MBA/2-MBA in the attractive ferments – also are in line with the previous analyses. Thus, the two different analytical approaches consistently reveal that 3-MBA/2-MBA and AA are associated with attractive and repulsive behavior of D. simulans to different genotypes of S. cerevisiae.
The Behavioral Read-Out of Single Volatiles Is Modulated by its Chemical Environment
The analyses so far implicate AA in repulsion and 3-MBA as the primary compound mediating attraction of D. simulans, respectively. We suggest that selection for yeast volatile production instigating a mutualism will have operated more strongly on yeast traits that attract insect vectors, not those that repel them, as the former are positively correlated with reproductive success for both species. Thus, we focused on disentangling the ecological scenarios under which 3-MBA attracts flies. There were two main questions we evaluated: 1) what concentrations elicit a response; and 2) are the behavioral stimuli affected by the background chemical context?
We directly quantified the concentrations of 3-MBA from liquid ferments in the attractive and repulsive yeast’s profile as 0.5 and 0.2 mg L−1, respectively. We first removed any effect of a background matrix and tested the behavioral response of flies to a range of 3-MBA concentrations (1 μg L−1 to 1 mg L−1; Fig. 2a) diluted in water against water. We observed no significant response of flies to any of these concentrations (all P > 0.06; see Fig. 2a). However, when the background matrix was increased in complexity by testing the response of flies to a range of concentrations of 3-MBA diluted in the same but unfermented grape juice against unfermented grape juice, significantly different behavioral responses were apparent (Fig. 2b). Flies were repelled by low concentrations of 1 μg L−1 (P = 0.048) and 10 μg L−1 (P < 0.001) 3-MBA, attracted to 25 μg L−1 3-MBA (P = 0.028; Fig. 2b grey circle) and indifferent to 1 mg L−1 (P = 0.33). Thus, the lack of a behavioral response to 3-MBA in water, but a significant, although complex response in grape juice, indicates that both the background matrix and concentration play a role in attraction.
Choice test response of Drosophila simulans to different concentrations (log-scale) of 3-methylbutyl acetate (3-MBA) in the context to the chemical environment (N = 6). Significantly different binominal distributions of flies are indicated by an asterisk α = 0.05). a Synthetic 3-MBA diluted in water and tested against water; b 3-MBA diluted in grape juice tested against grape juice; c 3-MBA diluted in grape juice and tested against 3-MBA (1 mg L−1) in grape juice; d 3-MBA diluted in grape juice and tested against acetic acid (25 μg L−1) in grape juice. 10-fold dilutions of 1 mg L−1 3-MBA are indicated by black symbols and others by grey symbols
Next, we evaluated whether it is the absolute concentration of 3-MBA or the relative difference in concentration that stimulates fly attraction. Since the T-maze system is an enclosed environment with limited airflow, the compound diffusion from both samples is likely to form a spatial gradient across both arms. We, therefore, tested a 3-MBA dilution series (1, 5, 10, 100, 1000 μg L−1) against a ‘high’ (1 mg L−1) 3-MBA background matrix (Fig. 2c). Here, the behavioral response changed significantly from repulsion at 5 μg L−1 (AI: −0.2; P = 0.007) to attraction (AI: 0.34; P < 0.001) at 10 μg L−1 3-MBA in grape juice. This later concentration was highly repulsive (AI 10 μg L−1: −0.36; P < 0.001; Fig. 2b) when tested against grape juice, indicating a shift in response to lower 3-MBA concentrations (Fig. 2c). This observation, together with the finding that up to 20-fold lower levels of 3-MBA than those measured from natural ferments were behaviorally active when tested in a system with reduced volatile complexity, is consistent with the hypothesis that it is differential 3-MBA concentrations that are ecologically important, not absolute concentrations.
Finally, we evaluated the role of AA in this system. This compound was found at levels of 0.4 and 0.1 g L−1 in liquid ferments of the repulsive and attractive yeast, respectively. The fly choice between a range of AA concentrations (from 0.25 μg L−1 to 500 mg L−1) against grape juice was tested, and significant repulsion was observed at AA concentrations of 2.5, 5, and 25 μg L−1 (all P < 0.03). We then evaluated the behavior of flies when exposed to varying concentrations of 3-MBA (5, 10, 25, 100, 500, 1000 μg L−1) against a repulsive AA matrix (25 μg L−1). Here, flies were either indifferent (5 μg L−1; 25 μg L−1 ; 0.1 mg L−1) or attracted to 3-MBA at concentrations of 10 μg L−1 (P = 0.009), 0.5 mg L−1 (P = 0.01) and 1 mg L−1 (P = 0.003; Fig. 2d). This indicates an interference effect of a repulsive background matrix (AA) to 3-MBA attraction. Moreover, no repulsion of 3-MBA was observed at any concentration against AA, suggesting that AA might be a more universal signal for repulsion in D. simulans.
Discussion
This study examined the ecological context of chemical communication between microbes and insects with particular focus on a mutualistic association. Here, we used the established and demonstrated interaction between Saccharomyces yeasts and Drosophila flies to evaluate whether the mode of chemical communication between them is ‘simple’ or ‘complex’ by scrutinizing single chemical components of their signals. We built on a recent study showing differential attraction between a range of S. cerevisiae genotypes and D. simulans (Buser et al. 2014). This behavior is beneficial for both parties, as flies have a demonstrable fitness increase when accessing yeast-infested fruits (Anagnostou et al. 2010; Becher et al. 2012), and are more fecund when associated with more attractive yeast isolates (Buser et al. 2014). More attractive yeasts are in turn more frequently dispersed by flies (Buser et al. 2014; Christiaens et al. 2014). We presupposed that attraction is a prerequisite for mutualism, and that those volatiles eliciting attraction shape the chemical recognition of mutualistic partners, whether coevolved or by chance.
In contrast to most other studies, we analyzed attraction and volatile compositions of yeasts when grown on natural, fruit-derived, and non-artificial media. First we attempted to narrow down the list of components that are associated with attraction by making use of the observation that attraction and repulsion of two S. cerevisiae isolates are similar when grown in liquid and solid fruit environments, despite considerable difference in volatile composition. Whether the environment is homogeneous or structured might affect the types of volatiles that yeast releases for at least two reasons. First, while the grape juice was identical, the physical nature of the matrix (fluid or solid) the yeast were growing in could reasonably affect the diffusion equilibrium of metabolic precursors to the cells, as well as the release of volatiles from the matrix and, thus, their concentrations in the headspace. Second, theory and some data suggest that the metabolic strategies employed by yeasts differ according to whether the environment is homogeneous or structured (Pfeiffer et al. 2001; MacLean and Gudelj 2006).
Drosophila simulans was able to distinguish between two S. cerevisiae isolates that produce an odor-space of qualitatively almost identical composition when grown in either liquid or solidified grape juice. Of the concentrations of 143 volatiles evaluated across liquid and solid ferments for both attractive and repulsive yeasts, just acetic acid and the two isomers 3-MBA (major component) and 2-MBA (minor component) were universally consistent in terms of their relative concentrations between attractive and repulsive yeasts: 3-MBA/2-MBA were associated with attraction and acetic acid with repulsion of D. simulans. At first glance, it might, therefore, appear that the nature of chemical communication between these organisms is relatively simple.
Single compounds and blends thereof have been classified as attractive or repulsive for D. melanogaster in previous studies and suggest a core set of proposed semiochemicals that can influence D. melanogaster behavior (Becher et al. 2012; Christiaens et al. 2014; Hutner et al. 1937; Knaden et al. 2012). It is of note that acetic acid has been consistently linked to D. melanogaster attraction in these experiments; not surprising given the common name of this species - vinegar fly. While 2-MBA is rarely discussed in literature, there are differences among D. melanogaster studies describing the response to 3-MBA, also known as banana oil or isoamyl acetate. Knaden et al. (2012) reported that 3-MBA was behaviorally neutral, whereas Christiaens et al. (2014) implicated this compound in D. melanogaster attraction. Ruebenbauer et al. (2008) studied variance in attraction of different D. melanogaster genotypes to various food sources and single compounds and found a low response to synthetic 3-MBA. However, high attraction of all strains was observed for banana and rotten banana, suggesting that single synthetic compounds confer only part of the odor information transmitted by complex, natural sources.
Using the less-well studied sibling species D. simulans, we found that 3-MBA is a likely semiochemical driving the yeast : fly mutualism, but only if presented in the context of a natural fruit source. Dilutions of the synthetic compound in water did not elicit any behavioral response in contrast to dilutions in grape juice. Further, the relative concentration showed a stronger effect on Drosophila behavior than the presence or absence of the compound itself. In natural ferments, attractive yeast consistently produced 3-fold increased levels of 3-MBA compared to repulsive yeast; Drosophila attraction, repulsion, and neutral behaviors towards synthetic 3-MBA in grape juice were observed, and these were concentration-dependent. Finally, the response to 3-MBA was altered further still when a repulsive compound was added to the system as part of the background odor, demonstrating context-dependent specificity of 3-MBA attraction to the chemical environment. Consequently, D. simulans requires 3-MBA to be part of a chemical blend to elicit attraction, and a behavioral response cannot be predicted by the presence or ultimate quantities of the compound per se. It is of note that levels of the minor isomer 2-MBA were correlated to 3-MBA production and the ratio of the two might impact attraction more strongly than the predominant ester alone. This implies that studies evaluating the allelochemical effect of single compounds might not achieve ecologically realistic responses.
In this study, 3-MBA concentrations from actual yeast ferments were 10–20- fold higher than those eliciting attraction of the synthetic compound in grape juice, suggesting antagonistic effects from other fermentation volatiles that were not present in spiked grape juice. Our experiments show that acetic acid is repulsive to D. simulans and can interfere with 3-MBA attraction when present as a background odor, shifting 3-MBA attraction towards concentrations that more closely resemble levels measured from natural ferments. Thus, the nature of chemical communication between these microorganisms and insects appears to be complex and involves a subtle interplay between semiochemicals, their relative concentrations, and context in terms of a suite of the background chemical matrix. These data are consistent with reports that insect behavior can be modulated by background odor (Schröder and Hilker 2008).
That D. simulans is repelled by acetic acid contrasts with consistent reports of this compound being attractive to D. melanogaster. One possible explanation for the opposite behavioral response in these sympatric species is that this difference may have evolved as a mechanism to mitigate competition. Because ethanol tolerance is correlated to acetic acid tolerance in D. melanogaster (Chakir et al. 1993), acetic acid can be hypothesized to effect selection of the ethanol-sensitive D. simulans in nature. In addition, acetic acid might be an indicator that fruits have been overrun by possibly less preferential microorganisms. The conversion of ethanol to vinegar by Acetobacter spp. is a natural end point of fermenting fruits, and so it seems plausible that yeast preferring flies might avoid this compound or show temporal separation of resource utilization (Joseph et al. 2009). The fruit substrate plays a crucial role in this interaction between yeasts and flies since it provides the precursors of volatiles as well as an energy source, but we did not investigate this third aspect. It will be of interest to evaluate how the semiochemicals involved in behavioral responses here translate to other types of fruit.
Pollinators can discriminate between floral phenotypes according to changes in odor intensity (same compounds, same ratio, different concentration), relative abundance (same compounds, same concentration, different ratio), and changes of composition (Cunningham et al. 2004; Sachse and Galizia 2003; Wright et al. 2005). Similar to floral scent, microbial volatile production can be viewed as a dynamic composite, changing its phenotype over time and in response to environmental factors such as temperature and nutrient availability (Smid and Kleerebezem 2014; Styger et al. 2011). The biological function of this mosaic of semiochemicals is likely to change accordingly.
From this study, we conclude that 1) single compounds (acetic acid and 3-MBA) can elicit different responses in the same or closely related species, and 2) single volatiles and blends thereof can act on members of different insect families. For example, Drosophilidae (Becher et al. 2012) and Nitidulidae (Phelan and Lin 1991) have been shown to be attracted to an almost identical blend of typical S. cerevisiae produced fermentation volatiles. Our study further demonstrates that D. simulans can be attracted or repelled by natural yeast ferments that contain volatile blends of similar composition, thus illustrating the difficulty in attempting to understand chemical communication by analyzing its constituents in isolation. Organisms navigate through a complex odor space that is influenced by background odors from the environment in addition to the olfactory targets. Therefore, it seems plausible that communication will have evolved to take place in this more complex ecological scenario. In summary, we provide a first step towards understanding the ecological context, and subtleties of chemical communication systems that drive mutualistic interactions of microorganisms and insects.
References
Anagnostou C, Dorsch M, Rohlfs M (2010) Influence of dietary yeasts on Drosophila melanogaster life-history traits. Entomol Exp Appl 136:1–11
Becher PG, Flick G, Rozpedowska E, Schmidt A, Hagman A, Lebreton S, Larsson MC, Hansson BS, Piskur J, Witzgall P, Bengtsson M (2012) Yeast, not fruit volatiles mediate Drosophila melanogaster attraction, oviposition and development. Funct Ecol 26:822–828
Bergström LGW (2008) Chemical communication by behavior-guiding olfactory signals. Chem Commun 34:3959–3979
Buser CC, Newcomb RD, Gaskett AC, Goddard MR (2014) Niche construction initiates the evolution of mutualistic interactions. Ecol Lett 17:1257–1264
Capy P, Gibert P (2004) Drosophila melanogaster, Drosophila simulans: so similar, yet so different. Genetica 120:5–15
Cha DH, Adams T, Rogg H, Landolt PJ (2012) Identification and field evaluation of fermentation volatiles from wine and vinegar that mediate attraction of spotted wing Drosophila, Drosophila suzukii. J Chem Ecol 38:1419–1431
Chakir M, Peridy O, Capy P, Pla E, David JR (1993) Adaptation to alcoholic fermentation in Drosophila- a parallel selection imposed by environmental ethanol and acetic acid. Proc Natl Acad Sci U S A 90:3621–3625
Christiaens JF, Franco LM, Cools TL, De Meester L, Michiels J, Wenseleers T, Hassan BA, Yaksi E, Verstrepen KJ (2014) The fungal aroma gene ATF1 promotes dispersal of yeast cells through insect vectors. Cell Rep 9:425–432
Cordente AG, Curtin CD, Varela C, Pretorius IS (2012) Flavour-active wine yeast. Appl Microbiol Biotechnol 96:601–618
Cunningham JP, Moore CJ, Zalucki MP, West SA (2004) Learning, odor preference and flower foraging in moths. J Exp Biol 207:87–94
Dobzhansky T, Cooper DM, Phaff HJ, Knapp EP, Carson HL (1956) Differential attraction of species of Drosophila to different species of yeast. Ecology 37:544–550
Drosophila 12 Consortium (2007) Evolution of genes and genomics on the Drosophila phylogeny. Nature 450:203–218
Haldane JBS (1955) Animal communication and the origin of human language. Sci Prog 43:385–401
Hallem EA, Carlson JR (2004) The odor coding system of Drosophila. Trends Genet 20:453–459
Hallem EA, Carlson JR (2006) Coding of odors by a receptor repertoire. Cell 125:143–160
Hutner SH, Kaplan HM, Enzmann EV (1937) Chemicals attracting Drosophila. Am Nat 71:575–581
Joseph RM, Devineni AV, King IFG, Heberlein U (2009) Oviposition preference for and positional avoidance of acetic acid provide a model for competing behavioral drives in Drosophila. Proc Natl Acad Sci U S A 106:11352–11357
Knaden M, Strutz A, Ahsan J, Sachse S, Hansson BS (2012) Spatial representation of odorant valence in an insect brain. Cell Rep 1:392–399
Liti G, Carter DM, Moses AM, Warringer J, Parts L, James SA, Davey RP, Roberts IN, Burt A, Koufopanou V, Tsai IJ, Bergman CM, Bensasson D, O’Kelly MJT, van Oudenaarden A, Barton DBH, Bailes E, Ba ANN, Jones M, Quail MA, Goodhead I, Sims S, Smith F, Blomberg A, Durbin R, Louis EJ (2009) Population genomics of domestic and wild yeasts. Nature 458:337–341
MacLean RC, Gudelj I (2006) Resource competition and social conflict in experimental populations of yeast. Nature 441:498–501
Palanca L, Gaskett AC, Günther CS, Newcomb RD, Goddard MR (2013) Quantifying variation in the ability of yeasts to attract Drosophila melanogaster. PLoS ONE 8, e75332
Pfeiffer T, Schuster S, Bonhoeffer S (2001) Cooperation and competition in the evolution of ATP-producing pathways. Science 292:504–507
Phelan PL, Lin H (1991) Chemical characterization of fruit and fungal volatiles attractive to dried –fruit beetle, Carphophilus hemipterus (Coleoptera: Nitidulidae). J Chem Ecol 17:1253–1272
R Development Core Team (2008) R: A language and environment for statistical computing. R Foundation for Statistical Computing, Vienna, Austria. http://www.R-project.org
Ruebenbauer A, Schlyter F, Hansson BS, Löfstedt C, Larsson MC (2008) Genetic variability and robustness of host odor preference in Drosophila melanogaster. Curr Biol 18:1438–1443
Sachse S, Galizia CG (2003) The coding of odor intensity in the antennal lobe: local computation optimizes odor representation. Euro J Neurosci 18:2119–2132
Saerens SMG, Delvaux FR, Verstrepen KJ, Thevelein JM (2010) Production and biological function of volatile esters in Saccharomyces cerevisiae. J Microbiol Biotechnol 3:165–177
Schröder R, Hilker M (2008) The relevance of background odor in resource location by insects: a behavioral approach. Bioscience 58:308–316
Smid EJ, Kleerebezem M (2014) Production of aroma compounds in lactic acid fermentation. pp 313–326. In Doyle MP, Klaenhammer TR (ed). Annu Rev Food Sci Technol 5
Steiger S, Schmitt T, Schaefer HM (2011) The origin and dynamic evolution of chemical information transfer. Proc R Soc B Biol Sci 278:970–979
Stökl J, Strutz A, Dafni A, Svatos A, Doubsky J, Knaden M, Sachse S, Hansson BS, Stensmyr MC (2010) A deceptive pollination system targeting Drosophilids through olfactory mimicry of yeast. Curr Biol 20:1846–1852
Styger G, Prior B, Bauer FF (2011) Wine flavour and aroma. J Ind Microbiol Biotechnol 38:1145–1159
Vosshall LB, Stocker RF (2007) Molecular architecture of smell and taste in Drosophila. Annu Rev Neurosci 30:505–533
Weiss I, Roessler T, Hofferberth J, Brummer M, Ruther J, Stökl J (2013) A nonspecific defensive compound evolves into a competition avoidance cue and a female sex pheromone. Nat Commun 4:2767
Witzgall P, Proffit M, Rozpedowska E, Becher PG, Andreadis S, Coracini M, Lindblom TUT, Ream LJ, Hagman A, Bengtsson M, Kurtzman CP, Piskur J, Knight A (2012) “This is not an apple”-yeast mutualism in codling moth. J Chem Ecol 38:949–957
Wright GA, Lutmerding A, Dudareva N, Smith BH (2005) Intensity and the ratios of compounds in the scent of snapdragon flowers affect scent discrimination by honeybees (Apis mellifera). J Comp Physiol A 191:105–114
Acknowledgments
The authors gratefully acknowledge Professor Edward J. Louis (University of Leicester, UK) and Professor Wittko Francke (University of Hamburg, Germany) for helpful comments on the manuscript. We also thank Robert Winz (Plant & Food Research Ltd, New Zealand) for support with GC/MS data analysis and Anne Barrington for providing access to the insect rearing facility at The New Zealand Institute of Plant & Food Research Ltd., Auckland. This work was funded by University of Auckland Research Grants and the Swiss National Foundation Grant to Matthew R. Goddard and Claudia C Buser.
Author information
Authors and Affiliations
Corresponding author
Rights and permissions
About this article
Cite this article
Günther, C.S., Goddard, M.R., Newcomb, R.D. et al. The Context of Chemical Communication Driving a Mutualism. J Chem Ecol 41, 929–936 (2015). https://doi.org/10.1007/s10886-015-0629-z
Received:
Revised:
Accepted:
Published:
Issue Date:
DOI: https://doi.org/10.1007/s10886-015-0629-z